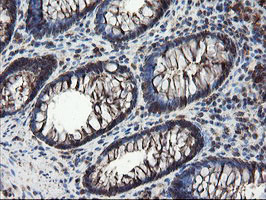
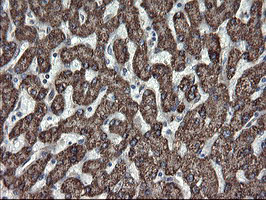
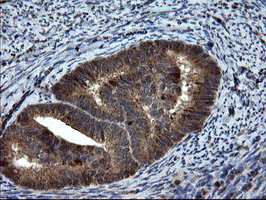

{{List.biaotou.product_name}}{{List.biaotou.catalog_number}}
Product Name
{{List.zonglan.product_name}}
Catalog Number
{{List.zonglan.catalog_number}}
Lot. No.
{{List.zonglan.lotno}}
Product Overview
Field of Research
{{List.chanwu.field_of_research}}
Concentration
{{List.zonglan.concentration}}
Applications
{{List.zonglan.application}}
Protein Length
{{List.danbai.protein_length}}
Nature
{{List.danbai.nature}}
Expression Host
{{List.danbai.expression_host}}
Species
{{List.danbai.species}}
AA Sequence
{{List.danbai.aasequence}}
Amino Acids
{{List.danbai.amino_acids}}
Tags
{{List.all.tags}}
Conjugate
{{List.all.conjugate}}
Molecular Weight
{{List.all.molecular_weight}}
Activity
{{List.all.activity}}
Endotoxin
{{List.all.endotoxin}}
Isoelectric Point
{{List.all.Isoelectric_point}}
Cellular Localization
{{List.all.cellular_localization}}
Host
{{List.kangti.host}}
Species Reactivity
{{List.kangti.species_reactivity}}
Immunogen
{{List.kangti.Immunogen}}
Specificity
{{List.kangti.specificity}}
Target
{{List.kangti.target}}
Cross Reactivity
{{List.kangti.cross_reactivity}}
Positive Control
{{List.kangti.positive_control}}
Conjugation
{{List.kangti.conjugation}}
Clone
{{List.kangti.clone}}
Isotype
{{List.kangti.Isotype}}
Purification
{{List.kangti.purification}}
Assay Type
{{List.shijihe.assay_type}}
Detection Method
{{List.shijihe.detection_method}}
Reactivity
{{List.shijihe.reactivity}}
Sample Type
{{List.shijihe.sample_type}}
Sensitivity
{{List.shijihe.sensitivity}}
Assay Range
{{List.shijihe.assay_range}}
Kit Components
{{List.shijihe.kit_components}}
Other Reagents Required
{{List.shijihe.other_reagents_required}}
Gene Name
Symbol
{{List.gongneng.symbol}}
ORF Size
{{List.gongneng.orf_size}}
Promoter
{{List.gongneng.promoter}}
Vector
{{List.gongneng.vector}}
Tag
{{List.gongneng.tag}}
Restriction Sites
{{List.gongneng.restriction_sites}}
Sequencing Primers
{{List.gongneng.sequencing_primers}}
Antibiotic
{{List.gongneng.antibiotic}}
Gene ID
mRNA Refseq
Protein Refseq
UniProt ID
Chromosome Location
{{List.gongneng.chromosome_location}}
Pathway
{{List.gongneng.pathway}}
Function
{{List.gongneng.function}}
Summary
{{List.gongneng.summary}}
Organism
{{List.xibaoxinxi.organism}}
Tissue
{{List.xibaoxinxi.tissue}}
Cell Type
{{List.xibaoxinxi.cell_type}}
Morphology
{{List.xibaoxinxi.morphology}}
Culture Properties
{{List.xibaoxinxi.culture_properties}}
Growth Properties
{{List.xibaoxinxi.growth_properties}}
Biosafety Level
{{List.xibaoxinxi.biosafety_level}}
Disease
{{List.xibaoxinxi.disease}}
Age
{{List.xibaoxinxi.age}}
Gender
{{List.xibaoxinxi.gender}}
Ethnicity
{{List.xibaoxinxi.ethnicity}}
Strain
{{List.xibaoxinxi.strain}}
Clinical Data
{{List.xibaoxinxi.clinical_data}}
Applications
{{List.xibaoxinxi.applications}}
Karyotype
{{List.xibaoxinxi.karyotype}}
Derivation
{{List.xibaoxinxi.derivation}}
Immunology
{{List.xibaoxinxi.Immunology}}
Fingerprint
{{List.xibaoxinxi.fingerprint}}
STR Profile
{{List.xibaoxinxi.dna_profile}}
Isoenzymes
{{List.xibaoxinxi.Isoenzymes}}
Cytogenetics
{{List.xibaoxinxi.cytogenetics}}
Receptor Expression
{{List.xibaoxinxi.receptor_expression}}
Genes Expressed
{{List.xibaoxinxi.genes_expressed}}
Antigen Expression
{{List.xibaoxinxi.antigen_expression}}
Comments
{{List.xibaoxinxi.comments}}
Complete Growth Medium
{{List.xibaoxinxi.complete_growth_medium}}
Sterility Tests
{{List.xibaoxinxi.sterility_tests}}
Viral Testing
{{List.xibaoxinxi.viral_testing}}
Viability
{{List.xibaoxinxi.viability}}
Population Doubling Capacity
{{List.xibaoxinxi.populationdoubling}}
Subculturing
{{List.xibaoxinxi.subculturing}}
Cryopreservation
{{List.xibaoxinxi.cryopreservation}}
Culture Conditions
{{List.xibaoxinxi.culture_conditions}}
Population Doubling Time
{{List.xibaoxinxi.population_doubling_time}}
Depositor
{{List.xibaoxinxi.depositor}}
Year of Origin
{{List.xibaoxinxi.year_of_origin}}
Passage History
{{List.xibaoxinxi.passage_history}}
Recommended For
{{List.peiyangji.recommended_for}}
Medium Kit
{{List.peiyangji.medium_kit}}
Components
{{List.peiyangji.components}}
Supplemented with
{{List.peiyangji.supplemented_with}}
Quality Control
{{List.peiyangji.quality_control}}
Instructions
{{List.peiyangji.Instructions}}
Form
{{List.chanpinshuxing.form}}
Concentration
{{List.chanpinshuxing.concentration}}
Purity
{{List.chanpinshuxing.purity}}
Preparation
{{List.chanpinshuxing.preparation}}
Reconstitution
{{List.chanpinshuxing.reconstitution}}
Storage & Stability
{{List.chanpinshuxing.storage}}
Storage Buffer
{{List.chanpinshuxing.storage_buffer}}
Applications
{{List.chanpinshuxing.application}}
Dilution
{{List.chanpinshuxing.dilution}}
Product Description
{{List.chanpinshuxing.product_description}}
-
{{item.content}}
-
{{item.user_name}} {{item.Createtime}}{{item.content}}Leading Biology: {{item2.Createtime}}{{item2.content}}
Recently Viewed Products
Clear All